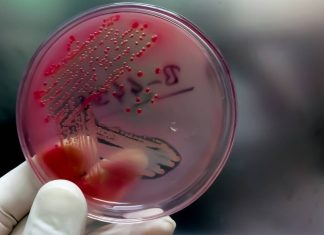
Sexually transmitted diseases that are increasing: gonorrhea, syphilis, monkeypox Sexually transmitted diseases that are increasing gonorrhea, syphilis, monkeypox

Tag: Sexually transmitted
Sexually transmitted diseases that are increasing: gonorrhea, syphilis, monkeypox
Sexually transmitted infections continue to increase, especially among young people. We explain what are the modes of contagion and the symptoms of three of those that have increased the most: gonorrhea, syphilis and monkeypox.
Gonorrhea:...